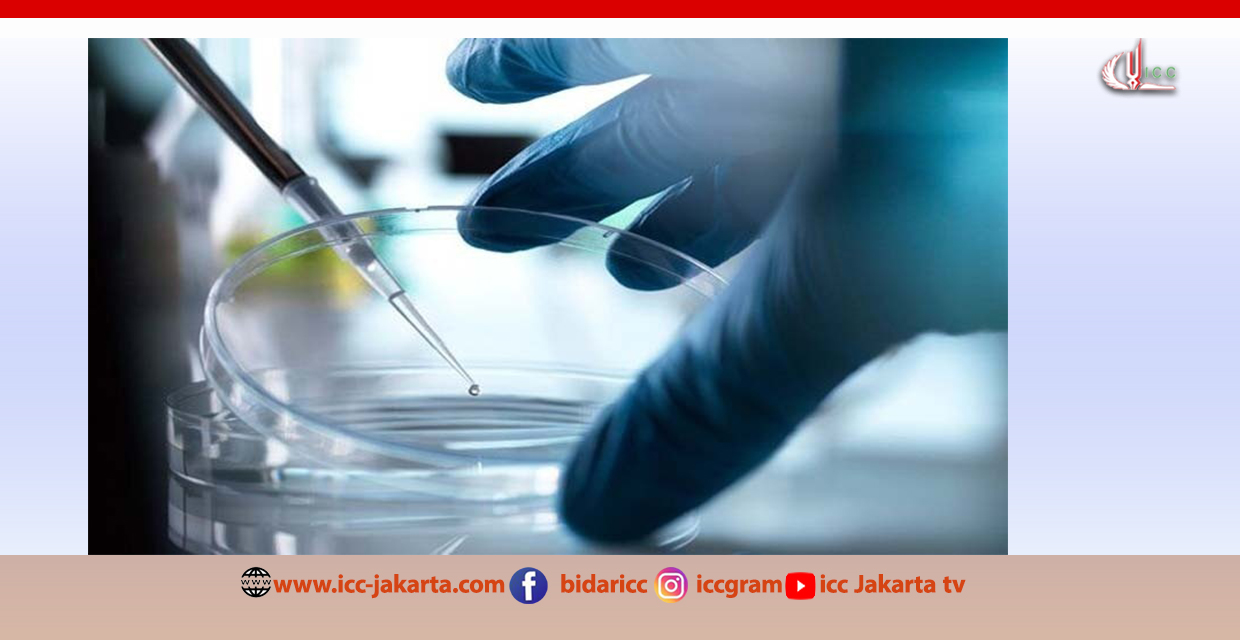

Sekretaris Jenderal Hizbullah, Sheikh Naim Qassem, melakukan wawancara televisi untuk pertama kalinya dengan Al-Manar pada hari Minggu, 9 Maret 2025. Wawancara ini memberi kesempatan bagi Sheikh Naim Qassem untuk berbicara tentang perkembangan terbaru di dalam Hizbullah, hubungan yang erat antara gerakan perlawanan dengan para pendukungnya, serta perjuangan yang terus berlanjut melawan pendudukan “Israel.”
Dalam wawancara tersebut, Sheikh Qassem memuji partisipasi luar biasa masyarakat dalam pemakaman almarhum Sayyed Hassan Nasrallah, yang menurutnya merupakan simbol solidaritas dan kesetiaan yang sangat mendalam. “Partisipasi rakyat dalam pemakaman ini sungguh luar biasa,” ujarnya, mengapresiasi solidaritas yang begitu besar di tengah masa yang penuh duka ini.
Sheikh Qassem kemudian menyerukan kepada para pendukung Hizbullah untuk tetap teguh dalam ketahanan mereka. “Saya mengajak kalian semua untuk tetap menjaga martabat, sebagaimana yang selalu kalian lakukan—karena kalian adalah anak-anak Sayyed Hassan Nasrallah,” katanya. Mengenang hubungan yang sangat erat antara pemimpin dan pengikutnya, beliau menambahkan, “Sekarang, saya semakin mengerti apa arti hubungan ini. Mereka adalah orang-orang yang paling mulia dan terhormat.”
Meskipun dihadapkan pada berbagai tekanan besar, Sheikh Naim Qassem menegaskan semangat juang yang tak tergoyahkan dari massa Hizbullah. “Dalam kondisi seperti ini, mereka adalah syuhada yang menunggu. Tidak ada yang bisa bermimpi untuk mengalahkan mereka,” tegasnya. Beliau juga menyampaikan rasa terima kasihnya atas solidaritas internasional yang luar biasa, mengucapkan terima kasih kepada “rakyat Palestina, Yaman, Tunisia, dan semua yang turut serta dalam pemakaman.”
Berbicara tentang peristiwa setelah kesyahidan Sayyed Hashem Safieddine, Sheikh Qassem mengungkapkan adanya diskusi internal di Hizbullah terkait pengambilan keputusan kepemimpinan. “Setelah syahidnya Sayyed Nasrallah, saya menghubungi Sayyed Hashem Safieddine untuk membahas persiapan pemakaman. Sebelum pemakaman, kami juga membicarakan posisi Sekretaris Jenderal sebagai inti kekuatan Hizbullah, dan saya memintanya untuk mengambil peran itu,” ungkapnya. Dalam konteks ini, Sheikh Qassem menegaskan bahwa keputusan kepemimpinan dalam Hizbullah tetap dilandasi oleh prinsip kebersamaan dan rasa tanggung jawab terhadap perjuangan.
Sheikh Qassem menggambarkan dampak pribadi dari pembunuhan Sayyed Hashem Safieddine terhadap dirinya, dengan mengatakan, “Ketika Sayyed Hashem Safieddine syahid, saya merasa seolah diguncang gempa bumi. Hidup saya terbalik, tetapi saya tidak merasa takut atau cemas—hanya ada petunjuk ilahi.” Meskipun begitu, beliau meyakinkan bahwa organisasi ini tetap solid dan kuat, dengan menegaskan, “Hizbullah adalah sebuah organisasi besar dengan kapasitas yang luar biasa.”
Di medan pertempuran, Sheikh Qassem mengonfirmasi bahwa evaluasi terus dilakukan untuk memastikan ketahanan dan kemampuan Hizbullah dalam beradaptasi. “Kami melakukan investigasi untuk mengambil pelajaran dan bertanggung jawab atas kejadian tersebut. Selain itu, kami sudah melakukan perubahan dalam strategi pertempuran itu sendiri,” jelasnya. Beliau juga menambahkan, “Kami telah mencapai kesepakatan gencatan senjata, namun kami tetap menjaga kekuatan penuh.”
Sheikh Qassem juga memberikan pandangannya mengenai perkembangan intervensi asing dan politik internal Lebanon. “Amerika akan campur tangan dalam penunjukan pejabat di Lebanon dan kami sedang membahas bagaimana menghadapinya,” katanya, menegaskan komitmen Hizbullah untuk mempertahankan kedaulatan Lebanon. Beliau menambahkan, “Kami tidak akan membiarkan tatanan baru ala ‘Israel’ berakar; kita harus membangun tatanan yang melindungi masa depan kita.”
Sheikh Qassem juga menekankan pentingnya kesabaran dalam perjuangan yang terus berlangsung. “Saya katakan kepada massa Hizbullah, kita harus bersabar. Pemimpin kalian, pejuang kalian, dan para pemuda kalian tetap akan berdiri teguh di garis depan,” serunya, mengajak untuk tetap bersatu dan terus berjuang.
Akhirnya, Sheikh Naim Qassem menujukan kata-katanya kepada pendudukan “Israel.” Pimpinan Hizbullah ini bertanya dengan tegas: “Bahkan jika kalian tetap berada di lima titik di Lebanon Selatan, berapa lama kalian akan bertahan? Perjuangan kami tidak akan membiarkan kalian terus ada di sana,” menegaskan bahwa perjuangan melawan pendudukan ini jauh dari selesai.
Sheikh Qassem juga menegaskan bahwa Hizbullah akan terus terlibat dalam proses politik Lebanon, dengan mengatakan, “Kami akan ikut serta dalam pemilihan dan telah sepakat dengan Gerakan Amal untuk memperbarui kesepakatan yang sebelumnya dibentuk antara Nabih Berri dan syahid Sayyed Hassan Nasrallah.”
Beliau juga menyoroti hubungan baik dengan berbagai faksi politik Lebanon, menyatakan, “Hubungan kami dengan Gerakan Patriotik Bebas tidak terputus, dan kami terus menjaga hubungan baik dengan Partai Demokrat, Marada, serta Partai Sosialis Nasional Suriah.”
Selain itu, beliau menegaskan kekuatan Iran yang tidak tergoyahkan, dengan mengatakan, “Iran memiliki kekuatan, martabat, kemampuan dalam mengambil keputusan, dan pemimpinnya sendiri.” Beliau menekankan bahwa kedaulatan dan independensi Iran tidak dapat dinegosiasikan, serta menegaskan kekuatan bangsa dan kepemimpinan negara tersebut.
Mengenai kemungkinan perang AS terhadap Iran, Sheikh Qassem menyatakan kekhawatiran yang mendalam, dengan mengatakan, “Saya percaya bahwa jika Amerika menyerang Iran, kerugiannya akan sangat besar, dan dampaknya terhadap dunia akan sangat luar biasa.”
Di tengah sesi wawancaranya, Sheikh Qassem masih terus menegaskan komitmen Hizbullah terhadap kedaulatan Lebanon, dengan mengatakan, “Negara bertanggung jawab atas rekonstruksi, dan kami akan membantu menambal setiap kekurangan yang ada.” Hal ini menegaskan posisi Hizbullah bukan hanya sebagai kekuatan militer, tetapi juga bagian penting dari kerangka politik dan sosial Lebanon.
Di akhir wawancara, Sheikh Qassem memberikan semangat kepada para pejuang Hizbullah, dengan mengatakan kepada mereka: “Kalian adalah mahkota dan warisan Sayyed Hassan Nasrallah, pemimpin para syuhada bangsa ini. Kalian telah mengatasi upaya musuh untuk menghentikan gerakan perlawanan dengan tekad dan kekuatan, serta telah menunjukkan citra terhormat gerakan perlawanan dalam prosesi pemakaman Sayyed Hassan Nasrallah.”
Sumber berita: https://en.abna24.com/
Sumber gambar: https://www.reuters.com/